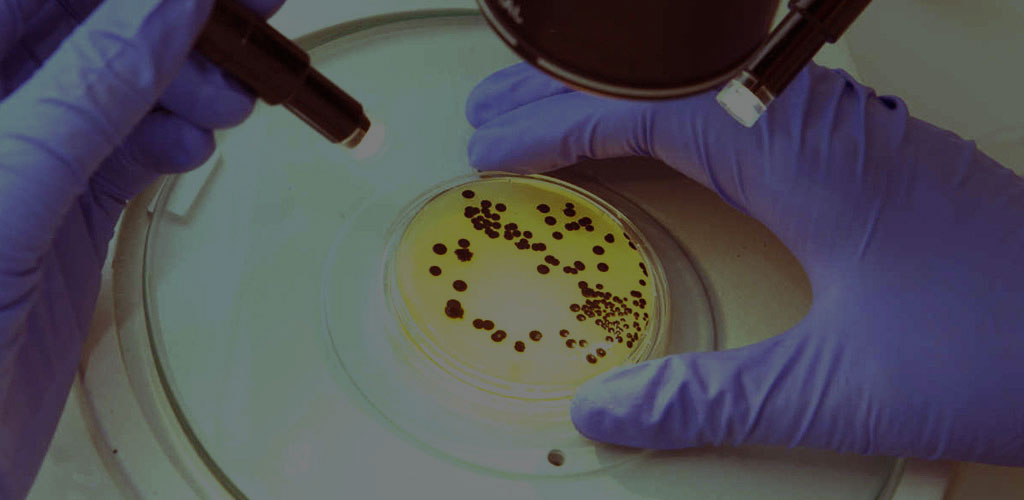
Studia biologiczne i przyrodnicze Trójmiasto (Gdańsk, Gdynia, Sopot)

Jak wyglądają studia biologiczne w Trójmieście?
Czym jest ochrona środowiska abiotycznego? Na czym polega neurofizjologia w diagnostyce chorób? Jak przeprowadza się analizę żywności? Na te, oraz inne pytania znajdziecie odpowiedź na studiach biologicznych i przyrodniczych w Trójmieście.
Studia biologiczne i przyrodnicze w stolicy województwa pomorskiego prowadzą dwie publiczne uczelnie, czyli Uniwersytet Gdański i Politechnika Gdańska. Realizują bogate programy nauczania, dostosowane do panujących wymogów na rynku pracy, a studentom oferują liczne praktyki oraz współpracę z wieloma firmami, wśród których znajdują się, między innymi: Orlen Laboratorium Sp. z o.o., Lotos Lab Sp. z o.o., Polpharma SA, Hamilton, Adamed, Laboratorium Synevo. Studia na pewno do łatwych nie należą, ale do satysfakcjonujących, jak najbardziej, tak. A jakie umiejętności można wynieść z bogatej siatki zajęć?
Posługiwanie się podstawowymi technikami inżynierii genetycznej, stosowanie metod eksperymentalnych w celu badania funkcji układu nerwowego, znajomość metod ochrony różnorodności biologicznej. A gdzie można je wykorzystać? W szkolnictwie, przemyśle syntezy organicznej, parkach krajobrazowych, laboratoriach badawczo- rozwojowych, organizacjach pozarządowych działających na rzecz ochrony przyrody i środowiska.
Na studentów czekają liczne koła naukowe, interesujące konferencje, a także ciekawe wydarzenia naukowe, takie jak: Noc Biologów, czy Dni Mózgu. Ponadto, zdobywanie wiedzy o otaczającym świecie może być ogromną frajdą dla kochających przyrodę, gdyż około 24% powierzchni miasta zajmują lasy i tereny zielone. Jeśli chcesz przyczynić się do rozwoju nauki, medycyny, przemysłu oraz nauczyć się jak dbać o środowisko, to wybierz studia biologiczne i przyrodnicze w Gdańsku.
Studia biologiczne w Trójmieście można podzielić na:
-
studia I stopnia (licencjackie lub inżynierskie)
-
studia II stopnia (magisterskie).
Studia biologiczne w Trójmieście e dzielą się na dwa podstawowe stopnie, które obowiązują na większości kierunków w Polsce. Osoby czujące, że nauki ścisłe takie jak biologia są w centrum ich zainteresowań, swoją przygodę z kształceniem wyższym zaczynają od studiów I stopnia. To, ile będzie ono trwać, zależy w dużej mierze od uczelni.
Nauka I stopnia na uniwersytetach trwa na ogół trzy lata i kończy się uzyskaniem tytułu inżyniera. Na politechnikach z kolei studenci podczas kształcenia I stopnia zdobywają wiedzę przez 3,5 roku (7 semestrów) i otrzymują tytuł inżyniera. Po zakończeniu studiów I stopnia czas na kontynuację nauki. Przyszli biolodzy, laboranci i naukowcy kształcą się na studiach magisterskich, które również mogą się od siebie nieco różnić.
Osoby decydujące się na dalszą naukę na uniwersytetach będą zdobywać wiedzę przez 2 dwa lata. Studentów politechnik czeka półtora roku nauki. Studia magisterskie to czas dopracowania wiedzy i doszlifowania umiejętności oraz oczywiście przygotowania do obrony najważniejszej pracy dyplomowej.
Studia biologiczne w Trójmieście rozpoczniesz jednak wyłącznie w trybie stacjonarnym, czyli dziennym. Dzieje się tak dlatego, że kierunki te są wyjątkowo wymagające. W przypadku kształcenia niestacjonarnego nie byłoby możliwe zrealizowanie całej podstawy programowej.
W przypadku nauki na studiach biologicznych w Trójmieście czeka cię mnóstwo ćwiczeń praktycznych oraz laboratoriów. Studia stacjonarne, czyli dzienne mają oczywiście bardzo dużo pozytywów – swoją wiedzę będziesz zdobywać w sposób regularny oraz nie będziesz musiał uiszczać opłat za czesne, ponieważ ten tryb nauki w przypadku państwowych uczelni jest po prostu bezpłatny!
czytaj dalej studia w Trójmieście
Czy studia biologiczne i przyrodnicze w Trójmieście są trudne?
Studia biologiczne i przyrodnicze w Trójmieście to zestaw licznych propozycji kształcenia, z których część oferuje pozyskanie szerokiej wiedzy biologicznej, a część wiedzy interdyscyplinarnej, na którą składają się także inne zagadnienia, reprezentujące między innymi chemię i inżynierię biochemiczną. Jak odpowiedzieć na postawione pytanie? Studia biologiczne i przyrodnicze w Trójmieście są trudne i bez mocnych podstaw z zakresu nauk biologicznych niełatwo przez nie przejść. Wystarczy zerknąć na obowiązujące programy kształcenia, aby zdać sobie sprawę z tego, iż studia te należą do wymagających. Z jakimi zagadnieniami spotykają się studenci? To między innymi: modelowanie molekularne, genetyka, mechanizmy patogenezy mikroorganizmów, fosforylacja u bakterii, immunologia komórkowa czy neuroendokrynologia.
Kierunki studiów biologicznych w Trójmieście:
Jeżeli wybierasz studia biologiczne w Trójmieście, to czekać na ciebie będzie bardzo interesująca oferta kierunkowa. Wśród propozycji ośrodków akademickich znalazły się takie pozycje, które zadowolą każdego fana nauk ścisłych oraz przyrodniczych. Pamiętaj, że biologia jako nauka ma dziś charakter interdyscyplinarny, a jej zdobycze wykorzystywane są w wielu innych dziedzinach – chociażby w medycynie.
Dziś także coraz częściej zwracamy się w stronę kwestii związanych ze świadomą eksploatacją zasobów materialnych oraz rozumiemy głębiej problemy ochrony środowiska. Kierunki, które oscylują wokół tych tematów również znalazły się w ofercie trójmiejskich ośrodków akademickich. Czekają na ciebie tradycyjne kierunki takie jak biologia, biotechnologia czy ochrona zasobów przyrodniczych.
Na szczególną uwagę zasługuje również kierunek taki jak biznes chemiczny. Jego studenci nie tylko otrzymają potężną dawkę ścisłej wiedzy. Poznają oni także tajniki zarządzania, które pozwolą im poruszać się swobodnie na dynamicznym rynku biznesowym. Osoby, które chcą otrzymać interdyscyplinarne, ścisłe wykształcenie mogą się zwrócić w stronę kierunków takich jak inżynieria biomedyczna czy bioinformatyka.
Kierunki biologiczne w Trójmieście - rekrutacja 2026/2027
-
biologia;
-
biotechnologia;
-
akwakultura – biznes i technologia;
-
biologia medyczna;
-
bioinformatyka;
-
biznes chemiczny;
-
genetyka i biologia eksperymentalna;
-
inżynieria biomedyczna;
-
ochrona zasobów przyrodniczych.
czytaj dalej kierunki studiów w Trójmieście
Gdzie studiować studia biologiczne w Trójmieście?
Studia pozwalają zdobyć wiedzę i umiejętności z zakresu m.in.: botaniki, różnorodności biologicznej, biotechnologii i ochrony środowiska. Absolwenci studiów biologicznych i przyrodniczych odnajdują się w pracy w laboratoriach biotechnologicznych, placówkach edukacyjnych, administracji państwowej, firmach kosmetycznych, ogrodach zoologicznych.
Studia biologiczne w Trójmieście możesz rozpocząć na trzech potężnych ośrodkach akademickich, które doceniane są nie tylko w Polsce, lecz także na arenie międzynarodowej. Zastanów się więc odpowiednio wcześnie, która z tych szkół spełni twoje wszystkie oczekiwania. Pamiętaj, że każda z nich ma odrobinę inny profil kształcenia.
Politechnika Gdańska, Uniwersytet Gdański i Gdański Uniwersytet Medyczny to trzy publiczne uczelnie, dzięki czemu w przypadku studiów stacjonarnych nie będą obowiązywać cię dodatkowe opłaty za czesne. Każdą z tych szkół wyższych cechują wysokie standardy dydaktyczne – możesz być zatem spokojny o jakość swojej zdobywanej wiedzy.
W przypadku Politechniki Gdańskiej otrzymasz wykształcenie inżynierskie, które otworzy ci drogę rozwoju w świecie techniki. Uniwersytet Medyczny sprawi z kolei, że otrzymasz wszechstronne wykształcenie nie tylko z biologii, lecz także chociażby z chemii, która ściśle współgra z naukami przyrodniczymi. Zastanów się odpowiednio wcześnie, jaka uczelnia w Trójmieście odzwierciedli twoje intelektualne oczekiwania!
Gdzie studiować kierunki biologiczne w Trójmieście:
-
Politechnika Gdańska;
-
Gdański Uniwersytet Medyczny;
-
Uniwersytet Gdański.
czytaj dalej studia w Trójmieście
Kierunki biologiczne - uczelnie publiczne (państwowe) w Trójmieście
-
Politechnika Gdańska;
-
Gdański Uniwersytet Medyczny;
-
Uniwersytet Gdański.
czytaj dalej uczelnie publiczne w Trójmieście
Jak wybrać studia biologiczne w Trójmieście, aby mieć dobrą pracę?
Każdy student, który idzie na studia, chciałyby wybrać kierunek gwarantujący w przyszłości dobrą pracę. Czy można jednak podjąć słuszną decyzję, kiedy jest się tuż po maturze? Jakimi zasadami należy się kierować, podczas wyboru studiów? Między innymi właśnie te trudne pytania zadaje sobie niemal każda osoba rozpoczynająca kształcenie wyższe.
Na samym początku zastanów się, czym właściwie chciałbyś zajmować się w przyszłości. Pamiętaj o tym, że studia biologiczne bardzo różnią się między sobą! Powinieneś zacząć więc od szczegółowego przeanalizowania oferty kierunkowej poszczególnych ośrodków akademickich. Czytaj opisy kierunków, zobacz, jak wyglądają ich programy kształcenia.
Kiedy już nabędziesz tę podstawową wiedzę, możesz zestawić ją ze swoimi oczekiwaniami, predyspozycjami i zainteresowaniami. Jeśli losy naszej planety nie są ci obce – wybierz taką propozycję, która pozwoli ci na realizację w tym obszarze.
A może fascynuje cię świat nauki i to właśnie w dyscyplinach biologicznych i przyrodniczych widzisz ogromny potencjał, który pozwoli przekraczać ludziom granice poznania? Uczelnie w Trójmieście również przygotowały kierunki spełniające te oczekiwania. Oferta jest bardzo bogata, więc jeśli tylko w kręgu twoich zainteresowań znajdują się przedmioty takie jak biologia, chemia czy nawet geografia i fizyka, to możesz mieć pewność, że studia biologiczne w Trójmieście przyniosą ci satysfakcję!
Co więcej – jeśli wybierzesz kierunek, który odpowiada twoim zainteresowaniom, to zrobisz już pierwszy krok przyczyniający się do znalezienia w przyszłości dobrej i satysfakcjonującej pracy. Podczas wyboru kierunków studiów zadaj sobie następujące pytania:
-
jaką wiedzę otrzymam podczas wszystkich semestrów nauki?
-
Czy umiejętności, które nabędę, pozwolą mi na zawodową realizację?
-
Co jest dla mnie ważne podczas zdobywania kwalifikacje?
-
Jakie obszary zawodowego rozwoju najbardziej mnie interesują?
To nie są łatwe pytania – zwłaszcza dla nastolatka. Pamiętaj jednak o tym, że studia mają sprawić, że w przyszłości nie będziesz musiał obawiać się o swoją pozycję na rynku zatrudnienia. Dobra praca powinna zadowolić cię nie tylko pod względem finansowym. Ona daje również satysfakcję oraz dalsze możliwości rozwoju!
Możliwe ścieżki rozwoju twojej kariery zawodowej:
-
nauczyciel;
-
naukowiec;
-
edukator ekologiczny;
-
laborant;
-
animator przyrody;
-
terapeuta zwierząt;
-
pracownik zoo;
-
biolog terenowy;
-
pracownik fundacji działającej na rzecz ochrony przyrody
-
czy nawet urzędnik!
czytaj dalej jakie studia wybrać
Jak wybrać uczelnię wyższą w Trójmieście?
Zdecydowałeś się, że rozpoczniesz studia biologiczne? Masz swój upatrzony kierunek? Jeśli odpowiadasz na te pytania twierdząco, to czas wybrać uczelnię w Trójmieście! Oferta stołecznych ośrodków akademickich jest bogata. Czy jednak każdy z nich będzie spełniać twoje oczekiwania?
Wybór może nie być taki trudny, jeśli podczas poszukiwań szkoły wyższej idealnej będzie ci towarzyszyć kilka podstawowych zasad! Na początku sprawdź, czy wybrany przez ciebie kierunek widnieje na stronie uczelni – to powinien być dla ciebie punkt wyjścia! Co dalej? Poznaj koniecznie uczelnię, którą wybierasz:
-
szczegółowo przenalizuj jej ofertę dydaktyczną;
-
sprawdź, jakie przedmioty znajdują się w programie kształcenia;
-
szukaj informacji i opinii w Internecie;
-
zaczerpnij porad znajomych.
Weź również udział w drzwiach otwartych uczelni! To najlepszy sposób, przy przeanalizować poszczególne oferty, poznać wykładowców, studentów oraz zaznajomić się ze wszystkimi szczegółami, które mogą być pomocne podczas podejmowania ostatecznej decyzji związanej ze studiowaniem!
czytaj dalej jak wybrać uczelnię
Czy studia biologiczne i przyrodnicze w Trójmieście to studia z przyszłością?
Obszar studiów biologicznych i przyrodniczych w Trójmieście złożony jest z rozmaitych kierunków. Kierunki te pozwalają pozyskać zarówno wiedzę ogólną, jak i specjalistyczną, otwierając tym samym drzwi do różnego rodzaju opcji zawodowych, różnych miejsc i stanowisk. Studia biologiczne i przyrodnicze w Trójmieście to studia z przyszłością, ponieważ pozwalają pozyskać także wiele umiejętności, które znajdują dość szerokie zastosowanie, w tym między innymi w: poszukiwaniach nowych leków i terapii czy badaniu funkcji układu nerwowego. Absolwenci mają zatem przed sobą szerokie morze zawodowych możliwości. Zdobyte wykształcenie mogą wykorzystać w placówkach medycznych, placówkach ochrony przyrody, biomedycznych firmach badawczo- rozwojowych, firmach farmaceutycznych czy podmiotach rozwijających technologie kosmetyczne.
Czy warto iść na studia biologiczne w Trójmieście?
Czy warto iść na studia? To pytanie zadaje sobie niemal każdy maturzysta, na którym spoczywa nie tylko wiele obowiązków, lecz także presja społeczna związana z nauką wyższą. Zanim podejmiesz ostateczną decyzję, zastanów się, jakie są twoje oczekiwania naukowe. Być może okaże się, że w swoim zawodowym życiu chciałbyś poświęcić się takiemu obszarowi, w którym dyplom uniwersytetu czy politechniki wcale nie będzie potrzebny.
Jeśli jednak pod uwagę bierzesz kierunki biologiczne, to może okazać się, że studia stanowić będą obligatoryjną część rozwoju twojej zawodowej kariery. Studia z tego obszaru warto wybrać przede wszystkim wtedy, jeśli w centrum zainteresowań znajdują się u ciebie przedmioty takie jak biologia, chemia, fizyka czy nawet geografia. Nie sprawiają ci one problemu? Jeśli tak, to świetnie – studia biologiczne czekają właśnie na ciebie!
Dlaczego naukę warto rozpocząć w Trójmieście? Przede wszystkim to właśnie tutaj będą na ciebie czekać trzy doskonałe ośrodki akademickie, które cechują najwyższe standardy nauczania. Kształcić się będziesz w dobrze wyposażonych laboratoriach, a nad jakością twojej wiedzy będzie czuwać kadra najlepszych wykładowców.
Studia biologiczne w Trójmieście staną się dla ciebie gwarantem doskonałej wiedzy i kwalifikacji, dzięki którym nie będziesz musiał obawiać się również o swoją zawodową przyszłość. Dziś bowiem inżynierowie, biologowie medyczni czy specjaliści do spraw związanych z ochroną środowiska nie muszą obawiać się o swoje zatrudnienie. Możesz mieć pewność, że wybierając studia biologiczne, inwestujesz w swoją przyszłość!
Praca po studiach biologicznych i przyrodniczych
Absolwenci studiów biologicznych i przyrodniczych w Gdańsku nie powinni narzekać na nudę po zakończeniu nauki. Zapotrzebowanie na specjalistów nie maleje, a konkretna droga zawodowa uzależniona jest od ukończonego kierunku i zgłębionej dziedziny.
Na przykład, absolwent kierunku Biologia medyczna, dzięki szerokiemu wykształceniu i zdobyciu bogatej wiedzy, między innymi z obszaru nauk przyrodniczych, nauk medycznych, nauk o zdrowiu i nauk o kulturze fizycznej, będzie mógł pracować w placówkach służby zdrowia, placówkach naukowo- badawczych, rehabilitacyjnych, pedagogicznych, resocjalizacyjnych, ośrodkach terapii uzależnień, wojsku i policji.
Posiada wiedzę pozwalającą współpracować ze specjalistami zajmującymi się chorobami genetycznymi i pasożytniczymi ludzi i zwierząt, analitykami i diagnostami medycznymi w zakresie wspomagania procesów diagnostycznych i terapeutycznych. Ponadto, czekają na niego laboratoria badawcze, kontrolne, diagnostyczne oraz praca w przemyśle farmaceutycznym i biotechnologicznym.
Absolwenci kierunku o nazwie Waloryzacja i zarządzanie zasobami przyrody znajdą zatrudnienie w firmach specjalistycznych zajmujących się ochroną środowiska i przyrody oraz edukacją ekologiczną, w działach ochrony środowiska firm i przedsiębiorstw, instytucjach odpowiedzialnych za finansowanie działań z zakresu ochrony środowiska (na przykład: Narodowy i Wojewódzki Fundusz Ochrony Środowiska i Gospodarki Wodnej, Fundacja Ochrony Środowiska), lasach państwowych, parkach narodowych, parkach krajobrazowych i rezerwatach, organizacjach pozarządowych działających na rzecz ochrony przyrody i środowiska, administracji publicznej.